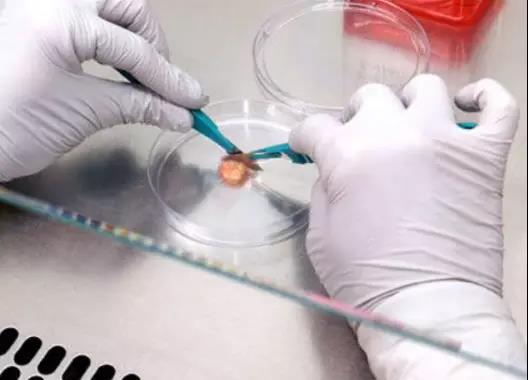

文章最后更新时间:2024-08-12 20:10:50,由春晓健康网负责审核发布,若内容或图片失效,请留言反馈!
1、惊人报道|每天小剂量伟哥可能减少结直肠癌风险!
科学家报道,每日一剂小剂量的伟哥可以显着降低动物模型中结直肠癌的风险,结直肠癌是导致癌症死亡的第三大原因。
乔治亚癌症中心和生物化学与分子生物学系的癌症研究员Darren D. Browning博士说,伟哥可减少一半的息肉形成,息肉是一种异常的肠道内衬细胞团,且常常无症状,但是息肉有变成癌症的可能。
伟哥可抑制结肠细胞中的天然存在的酶PDE5和其他可分解循环GMP组织,因此可用于减少细胞增殖并改善细胞分化,如分泌保护性粘液的杯状细胞。研究发现,针对循环GMP信号传导似乎是高风险患者的良好预防策略。
研究发现,在小鼠的饮用水中放置伟哥,减少了小鼠模型中的息肉,小鼠在腺瘤性结肠息肉病(APC)中有基因突变。与这些小鼠一样,携带APC基因突变的人可以在结肠和直肠内发展成百上千的息肉,并且基本上最终都会导致结直肠癌。同时,给幼年小鼠服用伟哥可以将这些动物的肿瘤数量减少了一半。
他指出,伟哥已经上市使用多年,以其放松血管周围平滑肌细胞的能力而闻名,用于多种剂量和年龄组人群,从早产儿肺动脉高压患者到勃起功能障碍老年人。Browning博士说,接下来应该包括对有结直肠癌高风险的人群进行药物临床试验,例如那些有强烈家族史、多发性息肉和慢性肠道炎症如结肠炎的患者。若试验取得可喜效果,伟哥将刷新适应症,用于癌症预防!
2、老药、新模型治疗肾上腺癌肿瘤减少77%!
一项研究,使用新模型来检测遗传靶点能为肾上腺癌提供有希望的治疗方法。一名患者接受14年获批的免疫药物派姆单抗(pembrolizumab)治疗,一年多后还持续药物治疗中,肿瘤减少77%,无新转移。

肾上腺癌很罕见,但依旧有人不幸患病。面临着令人沮丧的预后并且没有针对性的治疗方案,肿瘤学家压力很大。肾上腺皮质癌研究领域中最大的障碍之一是缺乏临床前模型,全国各地的团体试图建立肾上腺癌的细胞和动物模型,但尚未成功。没有一个合适的模型,评估潜在的新型疗法以及新药可能的副作用的能力会受到限制。
该团队成功利用患者组织建立了肾上腺皮质癌的“人源化”小鼠模型。这些人性化模型已经将人体免疫系统协同患者的肿瘤组织一起移植,使研究人员能够测试抗癌免疫疗法。因此,该组使用该人源化小鼠模型测试了FDA批准的免疫治疗药物派姆单抗,结果很可观。研究人员表示,罕见疾病通常需要基金会或私人捐助者的支持才能建立转化研究,肾上腺癌的研究已经打破瓶颈,获得初步成效,期待有朝一日FDA批准和更广泛治疗可用性的临床试验,造福更多肾上腺癌患者。
3、鳞状NSCLC:阿特朱单抗+化疗有望成为一线疗法!
根据III期IMpower131试验的一线调查结果,与单用化疗相比,阿特朱单抗(Tecentriq,atezolizumab)与化疗(卡铂和nab-紫杉醇)组合在一线治疗晚期鳞状非小细胞肺癌(NSCLC)患者时,能降低疾病恶化或死亡风险。本消息由Genentech(罗氏)公司发布,该公司是抗PD-L1制剂阿特朱单抗的生产商。
IMpower131研究的主要终点是无进展生存期(PFS)和总生存期(OS)。在中期分析中没有观察到统计学显着的OS改善,并且该研究现在依照其设计继续进行。atezolizumab组合没有出现新的安全信号。入组了1021例化疗初治的IV期鳞状NSCLC患者,随机1:1:1分为三组:使用atezolizumab、卡铂和紫杉醇(A组)进行前期治疗;atezolizumab、卡铂和nab-紫杉醇(B组);或卡铂和nab-紫杉醇的对照组(C组)进行治疗。

总体而言,41名可评估患者中有26名(63.4%)符合客观反应标准。atezolizumab加卡铂/紫杉醇组中8例患者中有4例(50%)达到客观反应(全部为部分反应)。16例atezolizumab加卡铂加nab-紫杉醇组中也有9例(56%)发生了应答。
“鳞状非小细胞肺癌难以治疗,在过去几十年中鲜有新的治疗方案出现,”基因泰克首席医学官兼全球产品开发负责人Sandra Horning博士说:“我们将与全球卫生监管机构分享IMpower131的结果,并期待看到更成熟的总体生存期数据。”
4、著名演员患喉癌透露其与口交经历有关引起医学关注!
五年前,当演员迈克尔道格拉斯坦率地透露他的喉癌与口交经历有关时,发生了两件事。他的发声让他的家人感到尴尬。但是他的确阐述了一个事实:一种名为人类乳头瘤病毒(HPV)引发了男性口腔癌的流行。
自那时以来,科学家们一直在研究为什么HPV具有明显的性别偏见。男性比女性更容易患口腔癌,这种病难发现、难治疗的疾病,已经超过了宫颈癌,成为美国最常见的HPV相关恶性肿瘤。
可以肯定的是,在过去几代人中,性规范的变化在这一令人震惊的趋势中发挥了作用。但研究越来越表明,真正的问题是男性实际上无法控制的问题:他们的免疫反应。

佛罗里达大学HPV研究人员Ashish A. Deshmukh说,与女性相比,男性更容易感染HPV,特别是高风险株。但很少能够自己消灭感染,并且更有可能得到再感染,原因不明。HPV是超过100种病毒的家族,可以生活在皮肤、子宫颈、阴道、肛门、外阴、阴茎、口腔和咽喉表面的细胞中存活,造成感染,甚至癌症。
目前,全球已经有三种HPV疫苗上市,国内有两种,分别为2价和4价。还有一种是9价,仅在美国、韩国、香港等地上市,这是保护效果最好的一种疫苗,能够预防9种HPV造成的感染,国内患者想注射9价疫苗可以通过全球肿瘤医生网咨询详细接种流程。
5、体外培养癌细胞验证抗癌要是否有效即将成为可能!
改善与癌症作斗争的重大障碍之一是增加人类抗癌药物有效性检测的问题,就像在患者体内一样的效果一样。
为了解决这个问题,制药公司开始在老鼠身上移植人类肿瘤。但老鼠不是人类,所以测试往往会导致死路一条。尽管可以在培养皿中培养肿瘤细胞,但它们跟实际癌症还一样。
一个名为TumorGenesis的公司开创了一种方法,该方法先提取患者的癌细胞,然后分析肿瘤的基因和蛋白质。这些信息至关重要,因为它可以指导细胞所需的营养物质和其他物质的选择。最后一步不是将癌细胞放在培养皿中,而是放在富含营养物的特殊支架上。它将有可能模仿身体内的肿瘤,在身体外部生长,来测试各种药物。
反过来,这将为癌症治疗和药物发现带来重大益处。实际上癌症是成千上万种不同的疾病,每个癌症都有不同的基础DNA突变。这就是为什么对一个人的卵巢癌有效的药物在另一个身上可能彻底无效。但如果能够体外培养患者的癌细胞,因此医生将能够在治疗患者之前测试药物组合,以发现哪些方法可行,从而使人们免受无效药物的副作用。
同样重要的是,制药公司将会研发比小鼠试验更好的方法来测试候选药物,且成本更低。这是实现个性化癌症治疗的又一关键步骤,可为每位患者提供更好的长期生存机会。
6、晚期淋巴瘤又一治疗方案获批!
昨日,美国FDA宣布批准Seattle Genetics的抗体药物偶联物Adcetris(brentuximab vedotin)与化疗联合治疗先前治疗过的的III期或IV期经典霍奇金淋巴瘤患者(cHL)。这一批准代表了40多年前引入临床实践的晚期霍奇金淋巴瘤的初始治疗方案的改进。
淋巴瘤是一种癌症,始于淋巴系统,免疫系统可帮助人体抵抗感染和疾病。淋巴瘤几乎可以在体内的任何地方发病,并可以扩散到附近的淋巴结。分为霍奇金淋巴瘤和非霍奇金淋巴瘤两种,大部分霍奇金淋巴瘤患者属于经典型,在这种类型的淋巴结中,有种大型的异常淋巴细胞(一种白细胞)被称为Reed-Sternberg细胞。通过早期干预,霍奇金淋巴瘤患者通常可以获得长期缓解。
在一项临床试验里,Adcetris治疗经典霍奇金淋巴瘤的潜力得到了验证——研究人员们招募了1334名经治患者,他们之前平均接受了6次以28天为周期的疗程。随后,他们被分为两组,一组接受Adcetris与化疗(AVD),另一组则只接受化疗(ABVD)。研究表明,相比只接受化疗的患者,接受组合疗法的患者,其疾病进展、死亡、或需要开始新治疗的风险降低了23%。
Adcetris结合抗体和药物,允许抗体将药物导向称为CD30的淋巴瘤细胞,获批治疗复发的经典霍奇金淋巴瘤、干细胞移植后有高风险复发或进展的经典霍奇金淋巴瘤、接受过其他疗法但都不起效的全身性间变性大细胞淋巴瘤、以及其他疗法不管用的原发性皮肤间变性大细胞淋巴瘤。
参考资料:
https://medicalxpress.com/news/2018-03-small-daily-dose-viagra-colorectal.html
https://medicalxpress.com/news/2018-03-endo-drugs-remarkable-response-adrenal.htmlhttp://www.onclive.com/web-exclusives/atezolizumab-plus-chemo-improves-pfs-in-frontline-squamous-nsclc
http://www.philly.com/philly/health/hpv-is-causing-an-oral-cancer-epidemic-in-men-by-outwitting-natural-defenses-20180309.html
http://homenewshere.com/online_features/family_living/article_88b2dcab-8ec7-5d77-bfdf-703ec39893f7.html
https://www.fda.gov/NewsEvents/Newsroom/PressAnnouncements/ucm601935.htm
声明:
推荐阅读:结直肠癌基因检测
声明:春晓健康网是服务与广大癌症肿瘤客户群体的综合性网站,提供癌症肿瘤相关问题交流咨询等服务,有这方面的需要可以直接点击右侧在线客服进行交流以及咨询!





发表评论